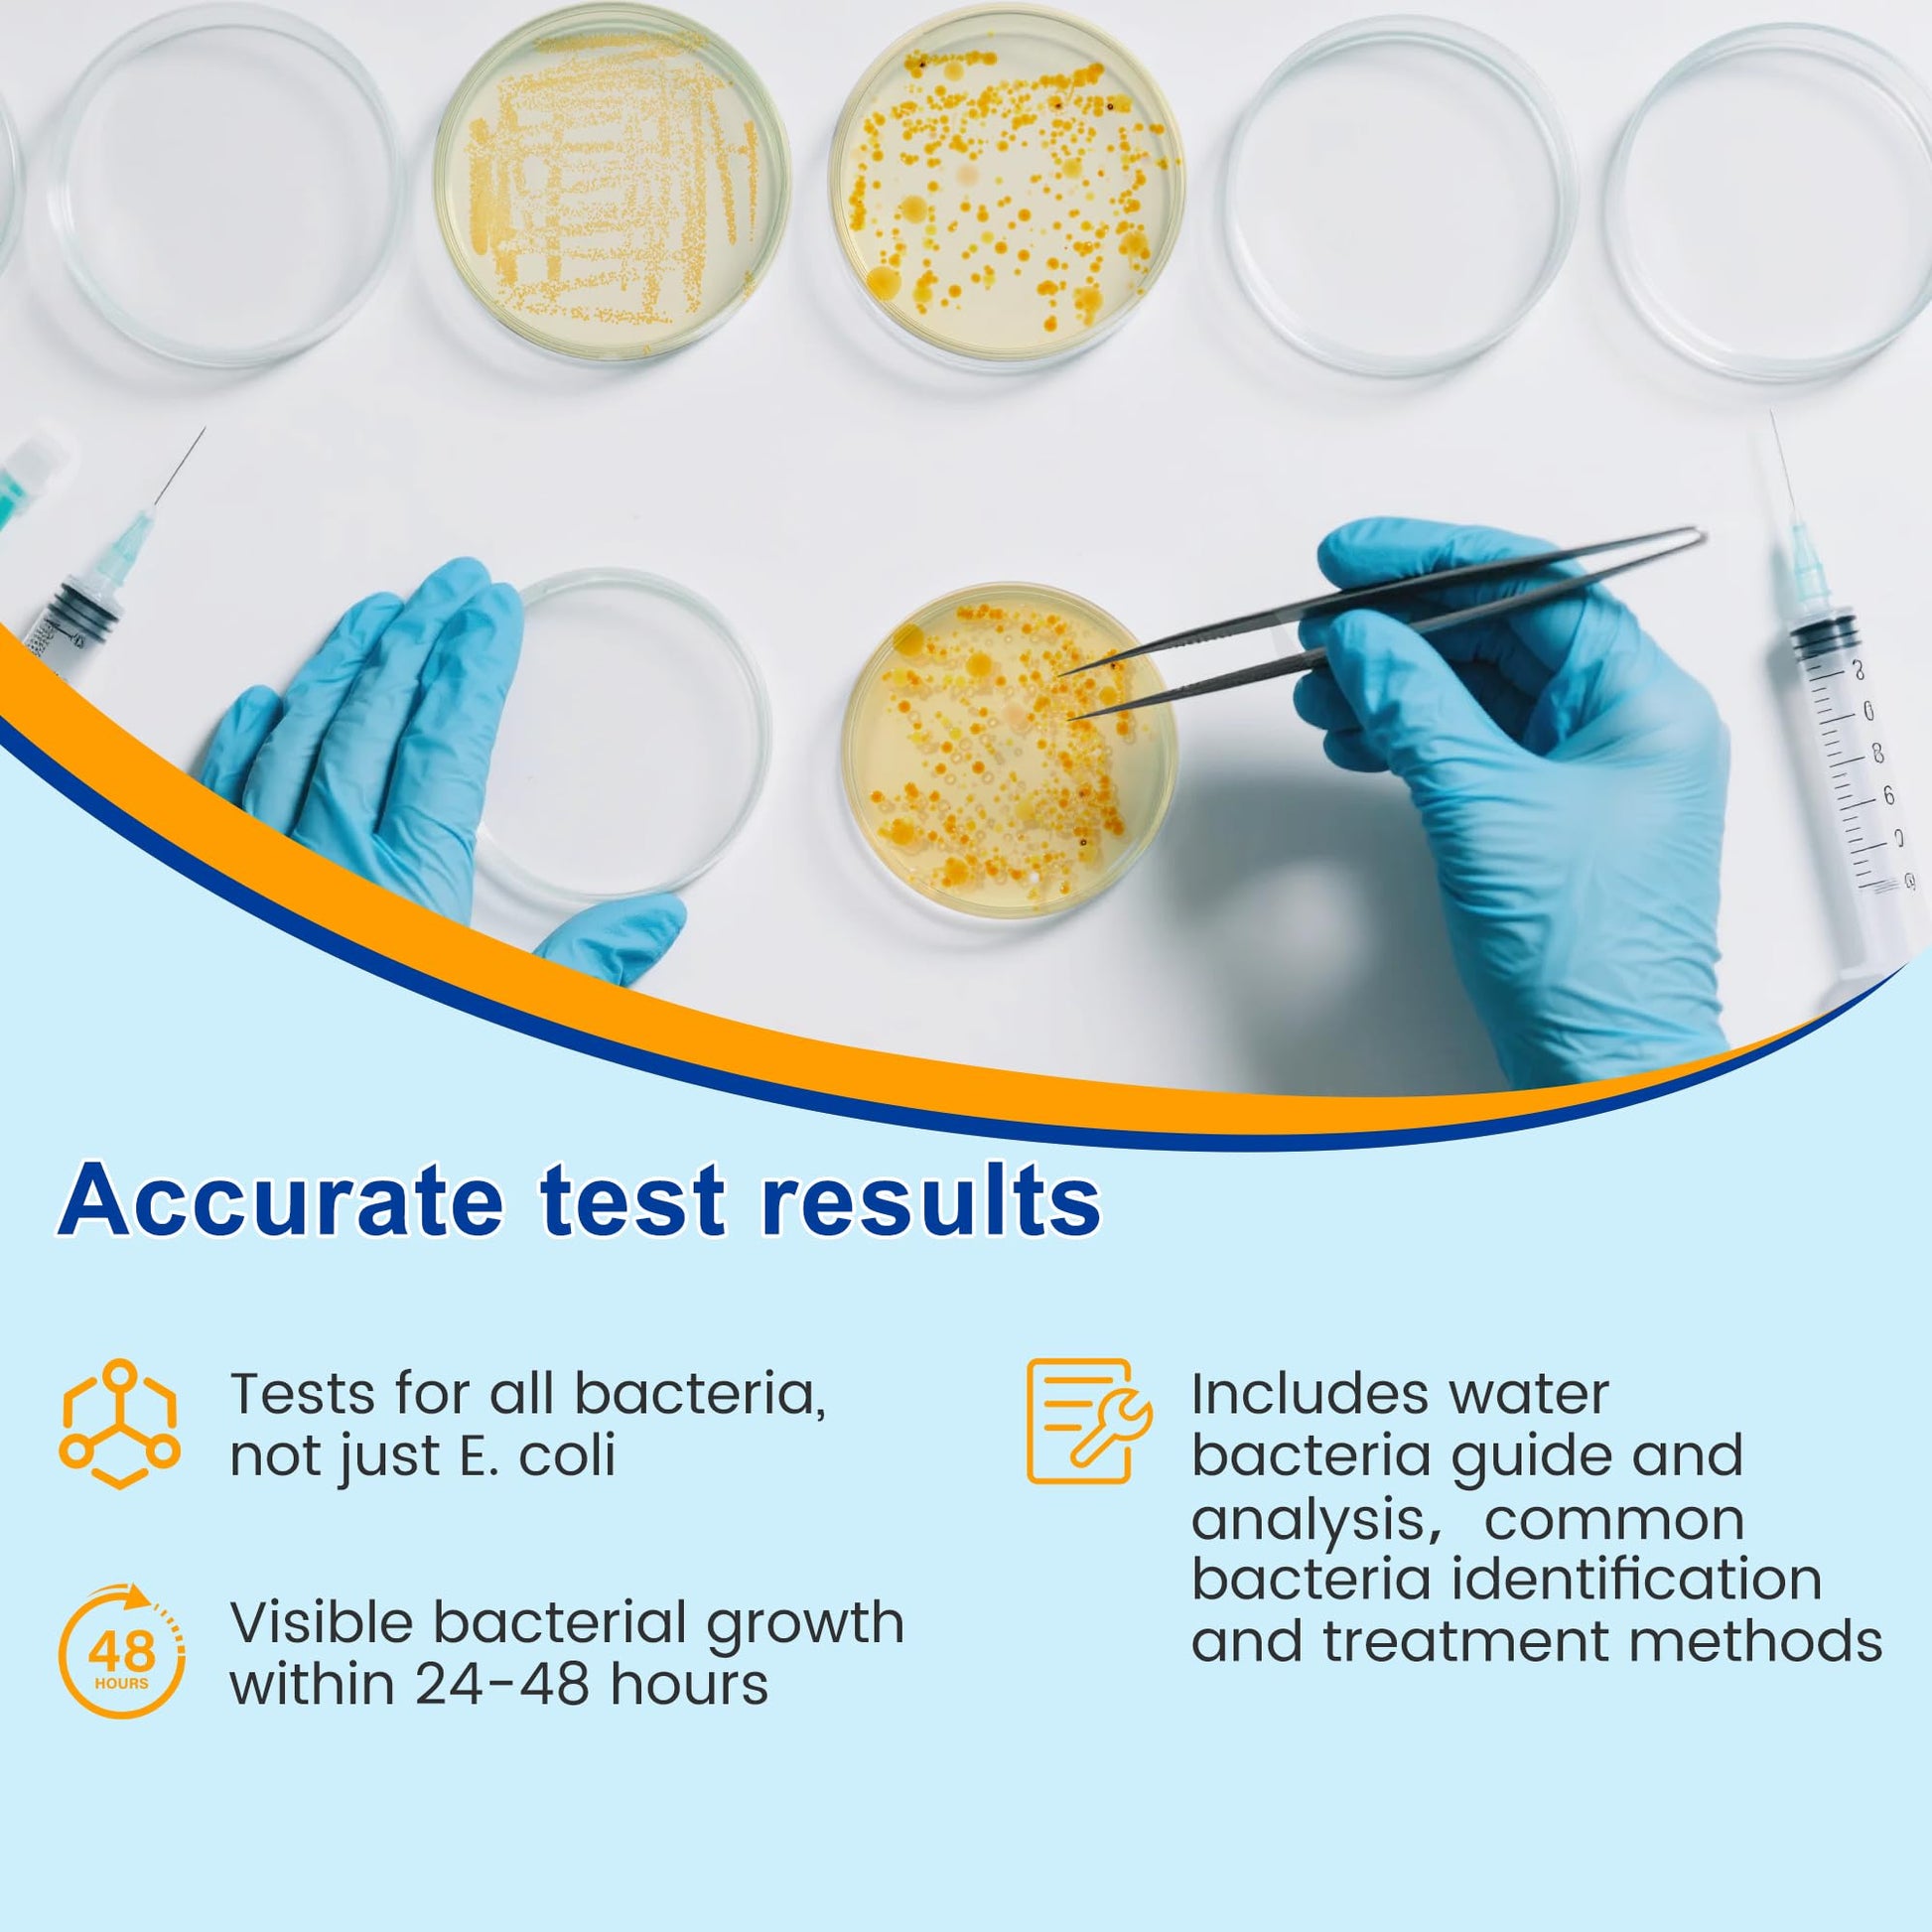

Funhaostar
Bacteria Test Kits for Drinking Water - 12 Tests Detect Coliform, E.coli & All Bacteria | Home Quality Testing Kit for Well, Tap, Pool, Hot Tub & City Water | Easy DIY Tester with Free Lab Analysis
Bacteria Test Kits for Drinking Water - 12 Tests Detect Coliform, E.coli & All Bacteria | Home Quality Testing Kit for Well, Tap, Pool, Hot Tub & City Water | Easy DIY Tester with Free Lab Analysis
Couldn't load pickup availability
Brand: Funhaostar
Features:
- 【Complete Water Testing Kit】- The Funhaosta Bacteria Test Kit includes 12 culture plates, detailed testing instructions, a bacterial identification guide with treatment recommendations, 12 sterile swabs, labeling stickers, testing gloves, and sealable bags. Everything is included - no additional supplies required!
- 【Accurate Test Results】- Unlike color-changing test strips, our kit allows you to visually observe bacterial growth within 24-48 hours on the culture plates, providing more reliable and verifiable results.
- 【Universal Water Testing】- Safely test all water sources including tap water, well water, pool water, aquariums, and more. Perfect for homes, RVs, camping trips, and outdoor use to ensure your water is bacteria-free.
- 【Detects ALL Bacteria】- Comprehensive testing for total bacterial contamination - not just E.coli/coliform. Identifies harmful bacteria like Salmonella, Staphylococcus aureus, Pseudomonas aeruginosa, and other common waterborne bacteria.
- 【FREE Expert Analysis】- Can't identify the bacteria? Simply send us clear photos of your culture plates for professional analysis. No need to mail samples - we'll provide a detailed bacteria analysis report!
- 【Water Safety Assurance】- Funhaosta's professional testing kit gives you peace of mind by ensuring your family's water safety. Our complete bacterial detection system helps prevent waterborne illnesses, protecting what matters most - your health and your loved ones.
Details: 【Complete Water Testing Kit】- The Funhaosta Bacteria Test Kit includes 12 culture plates, detailed testing instructions, a bacterial identification guide with treatment recommendations, 12 sterile swabs, labeling stickers, testing gloves, and sealable bags. Everything is included - no additional supplies required!
Package Dimensions: 8.3 x 4.7 x 4.6 inches
Materials
Materials
Shipping & Returns
Shipping & Returns
Dimensions
Dimensions
Care Instructions
Care Instructions







Image with text
Pair text with an image to focus on your chosen product, collection, or blog post. Add details on availability, style, or even provide a review.
-
Free Shipping
Pair text with an image to focus on your chosen product, collection, or blog post. Add details on availability, style, or even provide a review.
-
Hassle-Free Exchanges
Pair text with an image to focus on your chosen product, collection, or blog post. Add details on availability, style, or even provide a review.